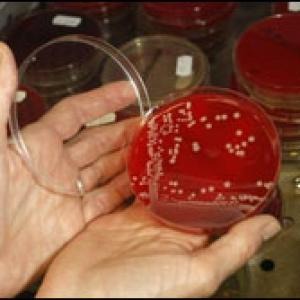
Бактериологические исследования

Витебская городская клиническая больница скорой медицинской помощи УЗ
Многопрофильное лечебно-диагностическое учреждение, оказывающее круглосуточно экстренную квалифицированную медпомощь. Стационарная высокоспециализированная медицинская помощь по неотложной хирургии, неотложной травматологии и ортопедии и др.
-
+375 (212) 43 65...arrow_drop_down
- +375 (212) 43 65 52 (Приемная главного врача)
- +375 (212) 43 65 80 (Приемный покой)
- +375 (212) 43 65 33 (Травматологический пункт)
- +375 (212) 43 65 76 (Справочная хирургического корпуса)
- +375 (212) 43 65 31 (Справочная терапевтического корпуса)
- +375 (212) 43 65 71 (Справочная акушерского корпуса)
- +375 (212) 43 65 70 (Платные услуги)
- +375 (212) 43 65 37 (Справки по платным услугам)
- +375 (212) 43 65 52 (Горячая линиия (по будням с 14.00 по 16.00))
- +375 (212) 43 65 46 (Прямая линия (по субботам с 9.00 по 12.00))
Бактериологические исследования
Витебская городская клиническая больница скорой медицинской помощи УЗ
Бактериологические исследования
Витебская городская клиническая больница скорой медицинской помощи УЗ
Житковичский районный центр гигиены и эпидемиологии ГУ
ЦГЭ. Осуществление государственного санитарного надзора.
-
+375 (2353) 5 46...arrow_drop_down
- +375 (2353) 5 46 72 (тел.)
Логойская районная ветеринарная станция ГУ
Ветеринарные и специализированные услуги. Квалифицированная консультация. Лечение, профилактика, вакцинация, лабораторные исследования, ветеринарно-санитарный надзор.
-
+375 (1774) 7 83...arrow_drop_down
- +375 (1774) 7 83 44 (Начальник)
- +375 (29) 702 72 73 (Начальник)
- +375 (1774) 7 81 75 (Общий отдел)
- +375 (1774) 7 81 46 (Тел.)
- +375 (33) 673 85 40 (Заместитель начальника)
- +375 (1774) 7 81 36 (Ветеринарный участок г. Логойска)
- +375 (1774) 2 29 47 (Ветеринарный участок г.п. Плещеницы)
- +375 (1774) 7 81 47 (Лаборатория)
Минская Областная Ветеринарная Лаборатория ГВСУ
Минская ОБЛВЕТЛАБОРАТОРИЯ. Ветеринарные и специализированные услуги. Квалифицированная консультация. Лечение, профилактика, вакцинация, лабораторные исследования, ветеринарно-санитарный надзор.
-
+375 (17) 231 55...arrow_drop_down
- +375 (17) 231 55 62 (Приемная)
- +375 (17) 328 40 03 (Зам. директора)
- +375 (17) 347 58 77 (Гл. бухгалтер)
Бактериологические исследования
Минская Областная Ветеринарная Лаборатория ГВСУ
Минский областной центр гигиены, эпидемиологии и общественного здоровья Государственное учреждение
Государственная регистрация и государственная санитарно-гигиеническая экспертиза. Лабораторные радиологические исследования. Государственный санитарный надзор. Предотвращение заноса, возникновения и распространения инфекционных и массовых неинфекционных заболеваний.
-
+375 (17) 374 46...arrow_drop_down
- +375 (17) 374 46 85 (Приемная)
- +375 (17) 396 03 47 (Факс)
- +375 (17) 378 55 16 (Бухгалтерия)
- +375 (17) 342 61 74 (Юрист)
Бактериологические исследования
Минский областной центр гигиены, эпидемиологии и общественного здоровья Государственное учреждение
 в избранном
в избранном